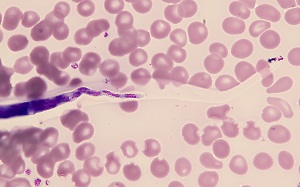
Case484_E parasitic image

Case #484 – January, 2019
A 36-year-old man, who has made 2-3 trips per year for the past 5 years to various countries in Africa, sought medical attention for a recent episode of angioedema of the face and arms. He reported being bitten by insects on most trips, but on a recent trip he confessed to not taking any recommended malaria prophylaxis. A blood smear was ordered mid-day, prepared and stained with Giemsa. Two objects of interest were detected on a thin smear. Figures A and B shows one object at 500x and 1000x oil immersion respectively; the other object is shown in Figure C at 500x and Figures D and E at 1000x oil immersion.
What is your diagnosis? Based on what criteria?

Figure A

Figure D

Figure B
Figure E

Figure C
Images presented in the dpdx case studies are from specimens submitted for diagnosis or archiving. On rare occasions, clinical histories given may be partly fictitious.
DPDx is an educational resource designed for health professionals and laboratory scientists. For an overview including prevention, control, and treatment visit www.cy118119.com/parasites/.